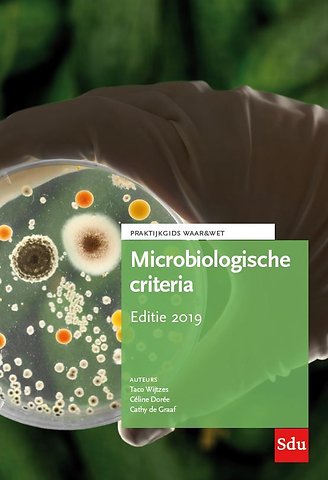

Microbiologische criteria - Editie 2019
Samenvatting
Voedingsmiddelen moeten veilig zijn en van goede kwaliteit. Een van de belangrijkste parameters voor veilig voedsel is de microbiologische gesteldheid van het product. Levensmiddelen mogen geen schadelijke micro-organismen bevatten in hoeveelheden die een onaanvaardbaar risico voor de menselijke gezondheid vormen. Grenswaarden worden vaak vastgelegd in de vorm van criteria. In deze praktijkgids vindt u tabellen waarin wordt weergegeven welke criteria er zijn voor diverse micro-organismen en voor welke voedingsmiddelen deze criteria gelden.
Verder vindt u in deze praktijkgids een overzicht van micro-organismen en hoeveelheden die maximaal zijn toegelaten in producten en productgroepen. Al deze informatie wordt overzichtelijk gepresenteerd in tabellen waarin u kunt vinden welke criteria er zijn voor diverse micro-organismen en voor welke voedingsmiddelen deze criteria gelden. Daarnaast wordt de bron weergegeven zodat het terugzoeken van de originele informatie eenvoudig is.
Grenswaarden voor voedingsmiddelen worden vaak vastgelegd in de vorm van criteria. Criteria geven aan wat de acceptabele grenzen zijn waar binnen voedingsmiddelen geconsumeerd mogen worden. Criteria kunnen in verschillende stadia van het proces of voor het product gelden, zoals bij inkoop van de grondstoffen, tijdens het productieproces, aan het begin van de houdbaarheidsperiode of aan het eind daarvan.
Het boek Microbiologische criteria is bij uitstek geschikt voor kwaliteitsmanagers werkzaam in de levensmiddelenindustrie en voor medewerkers van kwaliteitsdiensten en laboratoria. Ook studenten en docenten vinden in deze gids veel nuttige en praktisch toepasbare informatie.
Specificaties
Anderen die dit boek kochten, kochten ook
Net verschenen
Rubrieken
- aanbestedingsrecht
- aansprakelijkheids- en verzekeringsrecht
- accountancy
- algemeen juridisch
- arbeidsrecht
- bank- en effectenrecht
- bestuursrecht
- bouwrecht
- burgerlijk recht en procesrecht
- europees-internationaal recht
- fiscaal recht
- gezondheidsrecht
- insolventierecht
- intellectuele eigendom en ict-recht
- management
- mens en maatschappij
- milieu- en omgevingsrecht
- notarieel recht
- ondernemingsrecht
- pensioenrecht
- personen- en familierecht
- sociale zekerheidsrecht
- staatsrecht
- strafrecht en criminologie
- vastgoed- en huurrecht
- vreemdelingenrecht